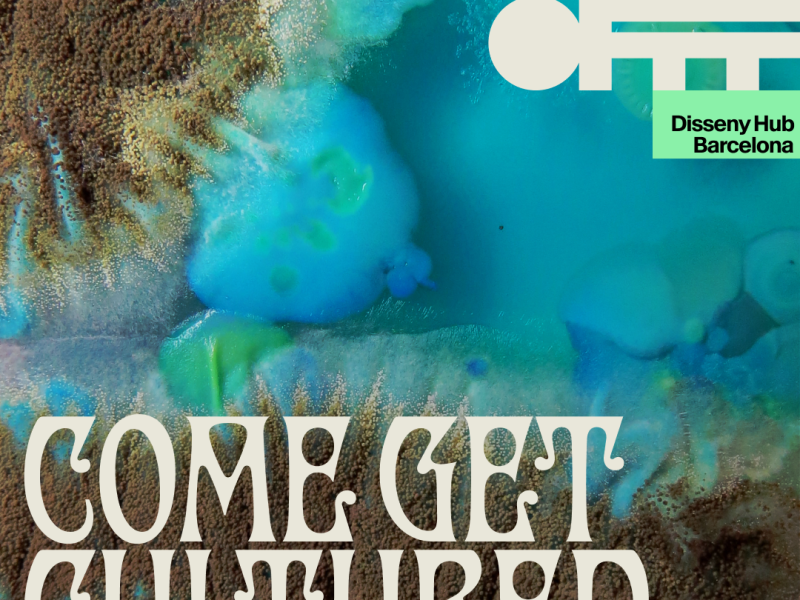
OFFF Barcelona 2026

¡ Mañana vas a flipar.. y es lo que hay!

La previsión lunes 6 de julio de 2026.
El viento soplará entre flojo y algo más fuerte en cualquier punto.
Leer más
Aumento consumo de crack en Barcelona.
Cuando dejas la política en manos de gente que no hace nada, es como cuando despides a la chica de la limpieza y piensas que la casa se limpiara sola..
Leer más
Monegros Desert Festival 2026
El Monegros Desert Festival es el evento de música techno más importante de España y quizás llegando a ser uno de los mejores del mundo.
Leer más
Share Festival 2026
En el forum de Barcelona, epicentro de muchos festivales y de distintos estilos en la ciudad condal, este 24 y 25 de julio se celebra el Share Festival.
Leer más
Okupación, el renting del futuro.
Paseando por la playa del Forum, he visto un asentamiento de tiendas de campaña, que llevan más de tres años ahí y nadie les ha dicho nada.
Leer más
Cruilla festival 2026
Hace ya más de veinte años, comenzaba su andadura uno de los festivales más importantes y diversos de la península, el Cruilla.
Leer más
O Son Do Camiño
La adaptación tan grande que tiene el humano, hace que hasta las malas decisiones acaben siendo lo que quieres.
Leer más
Marmingo: Salir un martes y volver un domingo.
La fiesta se ha convertido en algo intrínseco al ser humano y al ocio. Cada vez la gente está más enfiestada y el sistema además pone más medios para que eso siga en aumento
Leer más
Resurrection Fest 2026
Cuando ya has decidido que el metal es tu vida, Viveiro se convierte en tu casa. RESURRECTION FEST 2026
Leer más
Turismo y falsedad de las ciudades turísticas.
El turismo se ha convertido en una actividad socio económica de distracción de masas, donde todo vale para atraer el dinero de unos turistas ilusos
Leer más
Aquasella 2026
El mundo de los festivales, se está convirtiendo en una jauría económica, lleno de especuladores y humildes lobos económicos…
Leer más
Entrevista a Mar Gómez
En esta ocasión, la compañera Reina del Cielo entrevista a Mar Gómez, Meteoróloga, física, experta en
Leer más
Unwrapping SÓNAR
SÓNAR ha realizado varios videos y una sección dentro de su web llamada Unwrapping Sónar.
Leer más
Docs Barcelona 2026
En la actualidad, los procesos de captación de información del ser humano, han sido monopolizados por los medios audiovisuales.
Leer más

Gestión del tiempo
Cuando parece que haces de todo, luego resulta que no has hecho nada.Entonces cómo llegas al equilibrio del Yin yang.
Leer más
Bridal Fashion Week Bcn 2026
Garrapapero: persona que se cree burguesa, que no ha trabajado nunca, vividor fiestero, poli drogadicto de nivel intelectual semi bajo.
Leer más
OFFF Barcelona 2026
Todo lo que ves es realidad o retocado y creado por el humano, ahí está la diferencia de todo lo que existe.
Leer más
Sónar Festival 2026
En Barcelona, en junio y más precisamente este año el 18,19 y 20, se celebra el festival más importante de la ciudad condal.
Leer más
El invento de la inflación
La inflación es un invento creado para fastidiar las inquietudes ahorradoras de los trabajadores
Leer más
ELROW TOWN MADRID 2026
Madrid, 5 de marzo de 2026 – elrow Town Madrid anuncia el cartel completo de su edición 2026
Leer más
B-Travel Bcn 2026
Una de las medidas de la estupidez humana, es el interés por las cosas que tiene el humano. Cuando el humano turista, el interés que tiene donde va, es comprar souvenirs inútiles
Leer más
Alimetaria y hostelco 2026
Comer, la cosa más importante que tenemos que hacer, después de dormir, por la cual moriríamos si no lo hiciéramos y, por la cual morimos si lo hacemos mal.
Leer más
Sansan Festival Benicassim 2026
Si hay una comunidad autónoma que se lleva el premio a fiestera, organizadores de la ruta del bacalao y herederos de los genes de esa misma ruta..
Leer más
TALENT ARENA 2026
La motivación está en la zanahoria que usas para andar y la frase solo sé que no se nada…
Leer más
La policía del humor, adiós festival de Sants
En una época donde la gente tiene miedo a todo y la ignorancia se apodera de los miedosos…
Leer más
Festival MOSTRA 2026
En Barcelona ya hay una fecha y un festival que está instaurado como el comienzo de la temporada anual de festivales
Leer más
BULL BRIGADE presentan “Perché Non Si Sa Mai”
BULL BRIGADE presentan “Perché Non Si Sa Mai” sala Upload.
Leer más
La información de la desinformación.
Vemos que los medios audiovisuales están llenos de informadores que no tienen ni idea de lo que informan.
Leer más


Barcelona Wine Week 2026
El gran secreto de la felicidad en la sociabilidad, es que a ti te haga feliz hacer feliz a los demás
Leer más
Infraestructuras sin mantener.
Como todo en esta vida, la información y la experiencia transmitida de generación en generación, son la base de las buenas decisiones
Leer más
Julio Iglesias y los enanos crecidos.
Lo que estamos viendo ahora, es la hipocresía y falta de cultura, histórica y personal de la sociedad.
Leer más
Concierto TEENAGE BOTTLEROCKET
La banda estadounidense Teenage Bottlerocket, volverá a la península en mayo de 2026 para ofrecer tres conciertos muy esperados en Barcelona.
Leer más
ICE Barcelona 2026
Una vez que ya no crees en nada, porque te has dado cuenta que nada existe, lo mejor es encontrar lo que te divierta y hacerlo.
Leer más
Street Airbnb Barcelona
Una de las cosas que tienen que garantizar y que garantizan la mayoría de los sistemas socioeconómicos, es la vivienda.
Leer más
Valores, el algoritmo de las decisiones.
El algoritmo que nos guía en las decisión, son los valores.
Leer más
Migración, movimientos naturales…
Ya sabemos que los políticos no son de fiar, que utilizan cualquier causa social para subirse al carro de la misma y cazar votos.
Leer más
Navidad dextrosa navidad
Quien ha convertido la navidad en un concepto tan grande, agobiante, masificado y lleno de consumo por todos lados.
Leer más
PRIMITIVE MAN en Razzmatazz.
Tras más de una década marcando territorio en la escena extrema, Primitive Man se han consolidado como una propuesta que va más allá de la música
Leer más
Burocracia, el engaño de la rata.
El sistema socioeconómico de distracción de masas capitalista, hace aguas en sus dos vertientes opuestas, en Estados Unidos por demasiada libertad y en Europa por demasiado control y paternalismo.
Leer más
Cryptomonedas: OFFICIAL TRUMP
En el sistema en que vivimos, el mayor esfuerzo y trabajo que tienen que hacer los que mandan, es convencernos de que el dinero es útil.
Leer más
OMBRA Festival 2025
En Barcelona desde el 4 al 7 de diciembre Ombra Festival, un festival local que intenta dar luz a proyectos innovadores, donde el público pueda disfrutar de una mezcla real entre artistas y espacio.
Leer más
Black Friday
Recuerda, todo lo que tiene descuento, es que no tenía el precio correcto. Feliz Black Friday.
Leer más
Dart Festival 2025
En Barcelona del 10 al 14 de diciembre podéis disfrutar del festival DART, un festival documental especializado en la creación artística
Leer más
RUIDO JONDO
Barcelona acogerá el próximo sábado 22 de noviembre de 2025 la segunda edición de RUIDO JONDO
Leer más
Nuevas camaras de Control social.
Más zona verde, azul, impuestos, coches nuevos, combustibles caros, inflación, cámaras de control….
Leer más
Rufus T. Firefly en la sala Apolo1.
Este 28 de noviembre en la sala Apolo 1, tenemos la oportunidad de escuchar en directo al grupo Rufus T. Firefly
Leer más
Supermercados, mafiosos vestidos de cordero.
Los supermercados están espoliando al campo y a los ciudadanos con técnicas mafiosas y de trilero.
Leer más
Alquileres fuera del alcance local.
El precio de los alquileres se dispara en Barcelona por la demanda de teletrabajadores extranjeros.
Leer más
Creativa Barcelona 2025
En un mundo tan tecnológico y manipulado, vemos que últimamente la artesanía se está erigiendo como uno de los trabajos y hobbies más apreciados
Leer más
In-Edit Barcelona 2025
Te gusta la música, los documentales o el cine, In-Edit es la cita que no te puedes perder.
Leer más
Gastronomic Forum Bcn 2025
En cataluña, podemos decir que es una comunidad como casi toda españa, que ha tenido siempre una cultura de la buena comida.
Leer más
Mira Festival 2025
Con una mezcla de luz y música para el asuste e impresión del espectador, Mira Festival fue uno de los pioneros en darse cuenta, que los visuales iban a ser muy importantes en este futuro presente.
Leer másSe ha producido un error. Actualiza la página y/o inténtalo de nuevo.
Envianos tus videos y los publicaremos…. Barcelonanoticias45@gmail.com

Recibe las últimas noticias en tu mail.
! Si tienes algo que decir ¡
Barcelona noticias
LOS MUNDOS DE :
- 45″
- ACTUALIDAD
- Art Can Save the Planet
- ARTE
- Aviso legal
- Barcelona Noticias.cat
- BARES
- BICIS ROBADAS BCN
- Billares y juegos
- Blog
- Contacto
- DENUNCIA
- DEPORTES
- DISCOTECAS
- DOCUMENTALES
- El Mond de Enni Soler Magnet
- El tiempo en Bcn
- Entrevistas Reina del Cielo
- Equipo Barcelona Noticias
- EVENTOS
- FILOSOFÍA
- FOTO DENUNCIA
- HAPPY CHINOS
- HUMOR
- INTERNACIONAL
- Krusty Bars
- La Llama de oro
- Los mundos de Clark Que-és
- Los mundos de FAUSTO
- Los mundos de FRANK
- Los mundos de LENI
- Los mundos de:
- Muestra tu negocio.
- MUSEOS
- MÚSICA
- NACIONAL
- NO RECOMENDABLE
- OCIO
- REFLEXIONES INEFABLES
- RESTAURANTES
- RINCON DEL CAVA
- RSS
- SOCIEDAD
- TIENDAS















